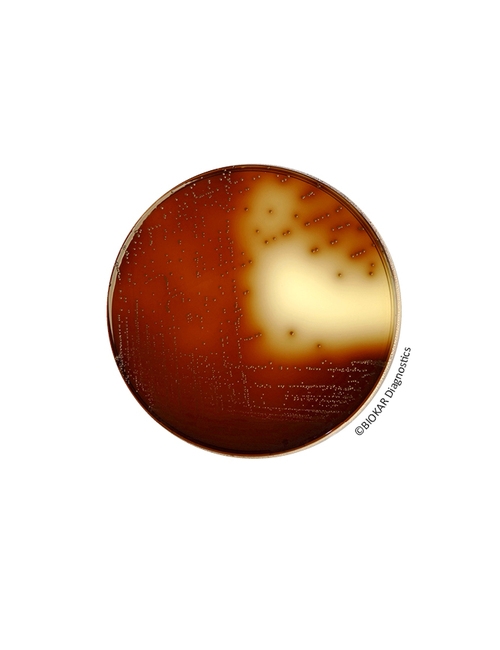
img

KF Streptococcus Agar (BASE)
KF Streptococcus Agar (BASE)
KF (Kenner Fecal) Streptococcus Agar, Petri kapları üzerinde klasik sayım teknikleri kullanılarak gıda ürünlerinde enterokokların izolasyonu ve sayımı için kullanılan seçici bir besiyeridir. Aynı zamanda, süt ürünlerindeki kirletici unsur olan enterokokların tespiti, asitlik başlatıcı laktik asit starterlerinin kompozisyonun için de standart olarak tavsiye edilmektedir.

Ürün Adı: KF Streptococcus Agar (BASE)
Ürün Kodu: BS02708
Miktar: 10 şişe
Ürün Adı: KF Streptococcus Agar (BASE)
Ürün Kodu: BK132HA
Miktar: 500 g
